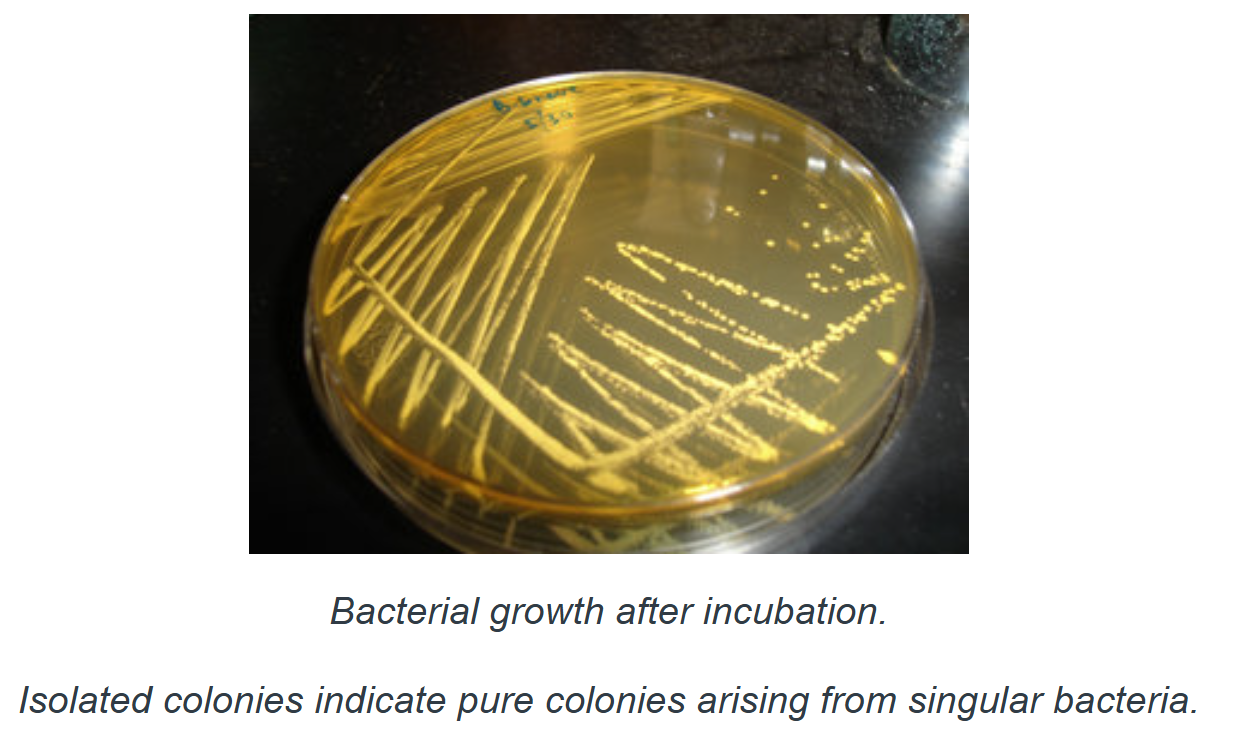
<ul><li><p><span style="font-family: "Century Gothic";"><span>Most material obtained from fish contain mixed pop of microorgs</span></span></p><ul><li><p><span style="font-family: "Century Gothic";"><span>to make detailed study of characteristics of indiv species comprising mixture you have to isolate them in pure culture</span></span></p></li></ul></li><li><p>4 diff kind of streaks </p></li><li><p><span style="font-family: "Century Gothic";"><span>plate now has mixed culture that you will now be able to remove individual and discrete colonies</span></span></p><ul><li><p><span style="font-family: "Century Gothic";"><span>each one represents one original bacterium</span></span></p></li></ul></li><li><p><span style="font-family: "Century Gothic";"><span>you can re-streak them and obtain pure culture bacteria after another pass to run tests for full ID</span></span></p></li></ul><p></p>

1/22
Looks like no tags are added yet.
Name | Mastery | Learn | Test | Matching | Spaced | Call with Kai |
|---|
No analytics yet
Send a link to your students to track their progress
Cocci
these are round and also referred to as spherical
Bacilli
rod-shaped
Successful pathogen
attach
enter
evade host defences
multiply
exit to re-infect
Motility
virulence factor that gives bacteria advantage to being successful
bacteria cells can move via flagella, cilia, gliding
Capsules
virulence factor that gives bacteria advantage to being successful
thin external envelopes produced by some cells that help to protect them from host immune cells (like avoiding phagocytosis)
Spores
virulence factor that gives bacteria advantage to being successful
bacterial stages resistant to destruction by heat or dehydration; allow org to survive through difficult environmental conditions
Glycocalyx
virulence factor that gives bacteria advantage to being successful
surface attachment mechanism that assists some bacteria in clinging to fish membranes
Cell wall
virulence factor that gives bacteria advantage to being successful
both Gram-+ and Gram-ve bacteria have cells but +ve bacteria is exposed and leads to staining characteristic
cell was = hydrophobic and helps bacteria to clump together and survive against attacks of host immune systems
Toxins
virulence factor that gives bacteria advantage to being successful
produced by gram+ and gram- bacteria ; may produce rapid death of invaded host or can reduce effectiveness of host immune response in variety of ways
some gram +ve orgs produce exotoxins in cytoplasm that're released from dead / live bacteria
gram -ves may produce endotoxins that're cell membrane components and released only on death of cell
Oxygen requirements
virulence factor that gives bacteria advantage to being successful
some bacterial species = anaerobic; can survive in tissues that've lost their blood supply
Systemic bacteria
some bacteria only cause disease once inside organ / tissue
they might be fine external of the fish but if where they aren't supposed to be --> bad
once inside they can use bloodstream to travel to all organs and tissues
getting in: through gut / intestinal wall, skin, lesions or sores, natural openings like lateral line / sensory pores, and parasites
External bacteria
cause skin + fin damage
not all are pathogenic; many bacteria existing normally on the skin will never cause disease
normal flora = protective and acts as competition for pathogenic bacteria
need to know what's normally present and which may be disease causing
Surface infections of fish
increase in numbers of bacteria in water where fish held
numbers increase, resulting increase in number of bacteria settling onto mucus layer
mucus defence eventually overwhelmed and can't adequately slough pathogens off
numbers build, bacteria through mucus and colonize skin
bacterial growth increase, skin damage starts → skin and gill damage results
Mechanisms of horizontal transmission
direct contact
through water
passively via fomites
actions of 3rd org like bird
Pathogenic bacteria
(bacteria) some specialized for invading living tissues
Saprophytes
bacteria that’re primarily environmental orgs
Gram’s stain
cell wall staining characteristics that lets you classify bacteria as Gram positive or gram negative
purple = gram-positive
red = gram-negative

Gram positive
stain purple because they have a dye called Gram's violet in their exposed peptidoglycan layer
retains crystal violet-iodine complex during alcohol decolourization
Gram negative
stain red cuz peptidoglycan layer hidden below outside layer and so they don't retain violet dye
thin peptidoglycan between inner/outer membranes, alcohol disrupts outer membrane, crystal violet washes out → safranin counterstain taken up → red/pink
Enrichment media
adding certain special growth enhancing substances to a basic nutrient medium so it supports growth of certain fastidious microorgs
Selective media
addition of specifical chemical substances that'll prevent growth of 1 group of bacteria without inhibiting others
ex. acids, antibiotics, dyes, etc.
Differential media
adding certain chemicals / reagents that'll result in a kind of growth / change in medium; lets observer differntiate between types of bacteria
like adding substance which can be precipitated or used in the growth of the colony so there's a visible change in the medium
Streak plate isolation
Most material obtained from fish contain mixed pop of microorgs
to make detailed study of characteristics of indiv species comprising mixture you have to isolate them in pure culture
4 diff kind of streaks
plate now has mixed culture that you will now be able to remove individual and discrete colonies
each one represents one original bacterium
you can re-streak them and obtain pure culture bacteria after another pass to run tests for full ID